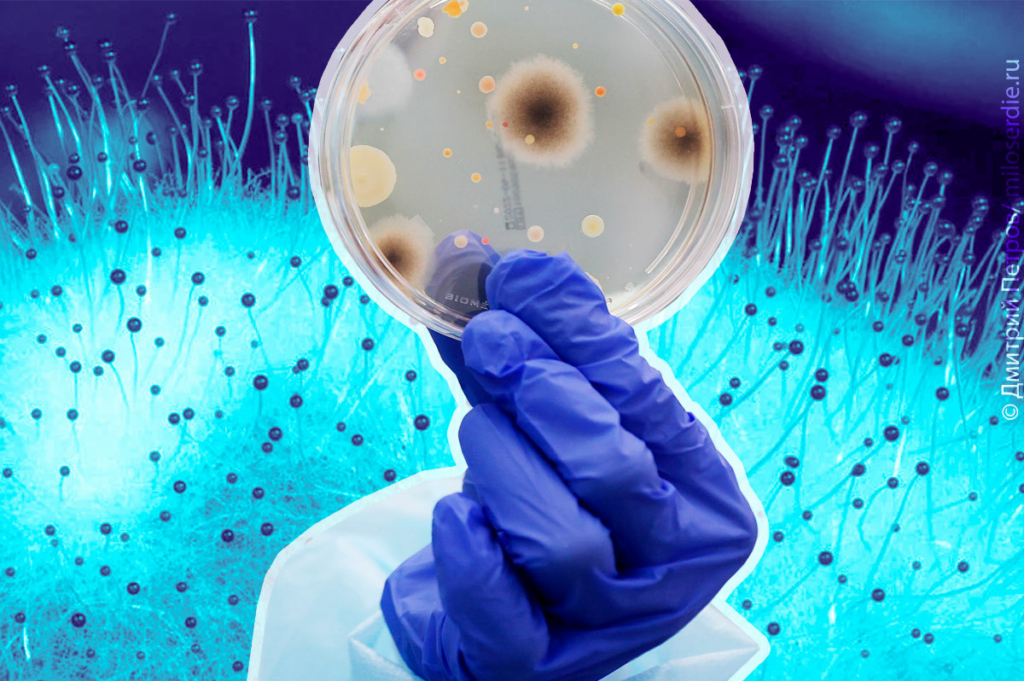
304

Налаживая систему постоянного внутреннего самоочищения, мы создаем стабильную прочность для организма и расширяем потенциал клеточного омоложения.
Легкость, высокий тонус, оптимизм, струящаяся энергия, внутренний огонь… Нам постоянно хочется что-то делать, к чему-то стремиться… Это означает — наша внутренняя система очищения работает «как часы». У нас получилось! Однажды пережив такое состояние, нам не хочется возвращаться в «не-энергию», «не-легкость», «несвежесть»… Внутренняя чистота тела влияет на мысли и чувства, которые также захотят чистоты. Наладить процесс постоянного самоочищения — проявить уважение и любовь к себе, как драгоценному творению. Это — не эгоизм, а мудрое подчинение великому закону выживания, в котором наше тело сконструировано как безупречно самоочищающийся «механизм».
Красивая реальность очищения
Когда мы своим мудрым поведением налаживаем процесс такого самоочищения — это делает нас неуязвимыми, так как дает постоянную перезагрузку организма.
Таким образом, мы замедляем старение, отвоевываем лишние десятилетия насыщенной, безболезненной, качественной жизни. Получив эти чудесные эффекты, мы можем радостно оглянуться назад и поблагодарить те мгновенья, когда «проснулись» и осознали в себе великий закон внутреннего самоочищения.
Симфония очищения
Очищение проходит по нескольким «дорожкам». Дорожка «гормоны» в большинстве случаев остается вне нашего внимания. Гормональное царство нам кажется сложнейшим хаосом. И, тем не менее, это четкая система, которая может обеспечить чистоту и неуязвимость, если мы проявим внимание к нему. Замусоренность в гормональном царстве создает каскад сложнейших разрушительных реакций, на которые мы можем влиять нашим мудрым образом жизни. При этом нам не нужно изучать эту сложность. Наша система самоочищения все сделает лучше, чем самые лучшие научные команды мира! Разве это не еще один повод изумиться нашему дивному устройству?!
Гормональные сюжеты
Гормоны создают для нас разные реальности, в зависимости от нашего образа жизни.
Красивые и некрасивые. В этих реальностях есть потери и приобретения, лучезарность и тусклость, заматерелость и утонченность, радость и апатия, энергия и бессилие, здоровое будущее и бесперспективность. Что реализуется — зависит только от нас.
Со временем гормоны накладывают на нашу внешность своеобразные «фильтры», как в фотошопе, делающие нас привлекательными или наоборот.
Постигая очищение, омоложение и оздоровление, мы помним не только о многослойности, но и о взаимосвязи между разными частями нас. Очищение на уровне гормонов зависит во многом от печени, крови и кишечника. Это слаженная команда «лучших игроков»!
Лишние гормоны
Печень очищает кровь, а кровь очищает печень. Когда печень перегружена «мусором», кровообращение резко уменьшается. Значит, наше самоочищение в ауте.
Усталая и перегруженная печень не сможет выводить из нас лишние гормоны, а не усталая, динамичная и «легкая» — оперативно избавляет нас от них.
У нас могут быть лишние гормоны?! В большинстве случаев так и бывает! Они создают токсичный и опасный, разрушающий и старящий нас «мусор».
Откуда берутся лишние гормоны? Они попадают в нас из внешнего мира и генерируются внутри
нас. Например, у нас может быть слишком много эстрогена. Химические вещества, имитирующие эстроген, прячутся в массе продуктов вокруг нас. Мы можем только рассчитывать на нашу печень, которая предельно внимательно сделает лучшую «уборку». Но она сделает это очень быстро, только если мы обеспечим ей легкость и ненапряжность. Счастливая печень будет изумительной нашей «уборщицей», а значит — спасительницей свежести и молодости. Вот, оказывается, куда ведет вся цепочка этого великого процесса очищения, если внимательно ее отслеживать!
Завуалированная реальность
Если мы хотим кое-что узнать об очищении, надо быть готовым к постоянным открытиям в своем организме. Так, чтобы печень хорошо нас очищала, работала на гормональный баланс, необходим глутатион. Глутатион — потрясающий антиоксидант, который крайне важен не только для самоочищения, но и для лечения многих хронических болезней. Когда внутри нас мало глутатиона — печень очищает нас очень плохо. А вот что снижает уровень глутатиона в организме:
- нездоровая еда (жареное, рафинированное и т.п.);
- ацетаминофен и другие фармацевтические препараты;
- тяжелые металлы (ртуть, стоматологические амальгамы, вакцины, татуировки);
- пестициды, гербициды;
- нитраты и другие пищевые консерванты химического происхождения (салями, хот-доги,
- ветчина, копчености и т.д.);
- искусственные подсластители и синтетические пищевые красители;
- алкоголь и сигареты;
- бытовая химия (синтетические ароматизаторы, моющие средства, смягчители тканей, освежители воздуха, нафталин, очистители, отбеливатели, и т.п.);
- некоторая посуда (антипригарное покрытие кастрюль и сковородок, пластиковые контейнеры).
Полностью избежать этих опасностей мы не сможем, но мы можем их минимизировать, мудро
меняя свои привычки.
«Ксено»
Как загрязняют нас коварные ксеноэстрогены? Их коварство в том, что они попадают в нас из внешнего мира, пользуясь нашим невежеством и полным равнодушием к себе. Это часть чужой для нас химии, которая, попадая в наш организм, начинает вести себя как гормон эстроген. Приставка «ксено» означает — «чужеродный».
Они создают дисбаланс в нашей гормональной системе. Ксеноэстрогены накапливаются в организме, в основном, в жировой ткани. Они парализуют настоящий эстроген, «связывают ему руки», чем создают каскад разрушений в нашем теле: от новообразований в молочных железах, яичниках и матке до потери костной ткани. Вот какую цену мы платим за равнодушие к себе!
Оказавшись в нашем теле, ксеноэстрогены воюют с нашими естественными гормонами, что приводит к сбою репродуктивной системы, переизбытку эстрогенов в организме.
Ксеноэстрогены коварно нам улыбаются из еды, косметики, бытовой химии… И мы, как зачарованные, бросаем в нашу покупательскую корзину колоссальное количество синтетического эстрогена, который прячется в дезодорантах, косметике, солнцезащитных кремах, пищевых консервантах, пластмассе, консервных банках, зубной пасте с темно-синей пометкой.
И не только
Источником «ксено» являются животные, которым дают синтетические препараты для ускорения роста и увеличения веса. Антибиотики, гормоны роста и синтетический эстроген из мяса животных перекочевывают к нам.
Если мы не уверены в том, каким образом взращивали животных, от произведенных из них продуктов лучше отказаться. Какая может быть альтернатива? Мне известны чудесные решения, когда несколько семей или человек коллективно финансировали тот или иной «сельский двор», чтобы условная «бабушка» взращивала экологичных животных для получения мяса и молока.Условная «бабушка» таким же образом может обеспечивать чистыми овощами и фруктами. Главное — доверие и не затратная по времени транспортная доступность. Таким образом, мы исключаем еще одну угрозу, ведь пестициды и гербициды, использующиеся для опыления садов
и огородов, спреи от насекомых пройдут мимо нас.
Еще один пласт «ксено»: мыла, шампуни, крема, лак для волос, дезодоранты, освежители воздуха,
лаки для ногтей. Решение — органическая косметика.
Синтетический эстроген прячется в противозачаточных таблетках. Сто раз подумайте о других решениях.
Гормональная угроза — бисфенол — живет и в пластиковых бутылках для воды, и в контейнерах для продуктов. Попадая в наш организм, он модифицирует рецепторы эстрогена. Нужно ли перечислять последствия? Решение — покупаем пластмассовые контейнеры с пометкой «без БФА» (BPA free), или создаем собственную воду, что легче и надежнее. Раньше я уже писала, как это делать легко и весело. Пропускаем через хороший фильтр воду из-под крана, переливаем в большую стеклянную, скажем, трехлитровую банку, куда на дно предварительно бросаем
камушки шунгита. Получаем минерализованную, чистую, качественную воду. Такое решение не для ленивых, равнодушных к себе людей. Очищающие и минерализирующие камни продаются почти в каждой аптеке целыми наборами «ассорти». Стоят недорого.
Высвобождение из плена
Как печень нас высвобождает из гормонального плена? После того, как печень разрушила лишние гормоны, отходы отправляются в кишечник, чтобы навсегда покинуть тело. Волокна (клетчатка), которую мы мудро едим каждый день (большая тарелка салата из листовой зелени, молотое семя сырого льна и др.) эффективно делают свою работу. Они приклеиваются к остаткам гормонов и блокируют их повторное всасывание в организм. Таким образом, мы освобождаемся от лишних гормонов и, кроме этого, улучшаем работу кишечника. Вот такое научное волшебство, которое омолаживает, очищает и оздоравливает.
Важные «леди» очищения
То, насколько успешно «плохие» гормоны будут нас покидать, зависит не только от печени и кишечника. В зоне нашего внимания должна быть еще одна стратегическая зона очищения, — эндокринная система, отвечающая за выработку естественных гормонов организма.
Не изменив питание, невозможно почистить также эндокринную систему и ее главных игроков: щитовидную железу, надпочечники и гипофиз.
Наш гипофиз живет в мозге. Ядро гипофиза оснащено нервными клетками с длинными волосками, которые беспрерывно мониторят то, что происходит в крови. Если гипофиз зафиксирует намного больше токсинов в крови, чем допустимо, он тут же извещает об этом щитовидную и надпочечную железы. Эти важные «леди» руководят процессом удаления токсинов из крови, выпроваживают «опасности» из нашего организма, если мы в тонусе и в здоровье. А если наш организм чрезмерно замусорен, то наши «леди» меняют тактику. Щитовидная железа
повелевает системе самоочищения выводить «мусор» через кожу, слизистые и серозные оболочки. Надпочечники прилагают массу усилий, выводя шлаки через почки и кишечник. От такой «внештатной», необычной работы железы засоряются. Каким путем пойдет очищение — зависит от того, какая железа «сильнее». Если щитовидная — очищение идет через кожу, слизистые или серозные мембраны.
Если надпочечники — очищение идет через почки, кишечник, печень.
Ускорить очищение можно зеленым чаем, в котором содержатся вещества, берущие в плен лишние гормоны и продукты их распада. Такой же эффект дает корица, рис, свекла и др. И, конечно, — чистая вода.
Хороший жир
Гормональную систему укрепляет «хороший» жир, который «живет» в семенах чиа, льна, тыквы, подсолнечника, сине-зеленых водорослях, авокадо… Он делает наши гормоны счастливыми, дает им потенциал для эффективной работы по нашему цветению. И все это на фоне здорового питания, зарядки и достаточного сна.
Конечно же, я не все охватила в плане этой дорожки очищения. Масса не менее важного осталась за рамками поста. Но это может дать импульс к размышлению, к пониманию того, как мы устроены, и, возможно, поднимет в нас желание жить в чистоте и благополучии на всех уровнях.
Налаживая систему постоянного внутреннего самоочищения, мы создаем стабильную прочность для организма и расширяем потенциал клеточного омоложения. Стоимость этих активов заключается в изгнании лени, инертности и пофигизма. Но, что важнее, — во включении мудрости, осознанности и «пробуждению» к высокому качеству жизни. И все это мы носим в себе! Главное — включить этот фееричный потенциал самоочищения.

 Источник: unsplash / Library of Congress
Источник: unsplash / Library of Congress
 Источник: unsplash / Library of Congress
Источник: unsplash / Library of Congress
 Источник: unsplash / Library of Congress
Источник: unsplash / Library of Congress










 Источник: unsplash / Jessica Christian
Источник: unsplash / Jessica Christian
 Источник: unsplash / Yichen Wang
Источник: unsplash / Yichen Wang
 Источник: unsplash / Pavel Aminov
Источник: unsplash / Pavel Aminov
 Источник: unsplash / Jessica Christian
Источник: unsplash / Jessica Christian
 Источник: unsplash / Lobacheva Ina
Источник: unsplash / Lobacheva Ina
 Источник: unsplash / Jovan Vasiljević
Источник: unsplash / Jovan Vasiljević
 Источник: unsplash / Sophia Lasheva
Источник: unsplash / Sophia Lasheva
 Источник: unsplash / Salah Darwish
Источник: unsplash / Salah Darwish
 Источник: unsplash / n
Источник: unsplash / n
 Источник: unsplash / Hector Reyes
Источник: unsplash / Hector Reyes
 Источник: unsplash / Zoe Fitzgerald
Источник: unsplash / Zoe Fitzgerald
 Источник: unsplash / Jordan Bigelow
Источник: unsplash / Jordan Bigelow
 Источник: unsplash / BenMoses M
Источник: unsplash / BenMoses M
 Источник: unsplash / Ian Talmacs
Источник: unsplash / Ian Talmacs
 Источник: unsplash / Cami Cam
Источник: unsplash / Cami Cam
 Перепелиные яйца
Перепелиные яйца Врачи относятся к перепелиным яйцам как к лечебно-диетическому продукту (shutterstock)
Врачи относятся к перепелиным яйцам как к лечебно-диетическому продукту (shutterstock)
 Перепелиные яйца содержат много витаминов и минералов, необходимых для женского здоровья (shutterstock)
Перепелиные яйца содержат много витаминов и минералов, необходимых для женского здоровья (shutterstock)
 3–4 перепелиных яйца в день достаточно для поддержания здоровья
3–4 перепелиных яйца в день достаточно для поддержания здоровья
 Сырые перепелиные яйца лучше не употреблять: риск проблем со здоровьем существует
Сырые перепелиные яйца лучше не употреблять: риск проблем со здоровьем существует
 Если вам кажется, что отучиться грызть ногти на руках легко – вы сильно ошибаетесь. Любой стресс, даже самый незначительный, и вот уже человек бессознательно тянет пальцы в рот. Однако специалисты настаивают: грызть ногти нельзя. Во-первых, это портит их внешний вид, а во-вторых, может серьезно отразиться на здоровье.
Если вам кажется, что отучиться грызть ногти на руках легко – вы сильно ошибаетесь. Любой стресс, даже самый незначительный, и вот уже человек бессознательно тянет пальцы в рот. Однако специалисты настаивают: грызть ногти нельзя. Во-первых, это портит их внешний вид, а во-вторых, может серьезно отразиться на здоровье. Фото: Unsplash, Marissa de Kogel
Фото: Unsplash, Marissa de Kogel
 Фото: Shutterstock
Фото: Shutterstock



 При дроблении в ячмене сохраняется больше ценных веществ, чем при шлифовке зерен (shutterstock)
При дроблении в ячмене сохраняется больше ценных веществ, чем при шлифовке зерен (shutterstock)
 Ячневая каша с фруктами и ягодами — это один из самых полезных завтраков (shutterstock)
Ячневая каша с фруктами и ягодами — это один из самых полезных завтраков (shutterstock)
 Витамины, микроэлементы и белок — все это делает ячку полезной для спортсменов (shutterstock)
Витамины, микроэлементы и белок — все это делает ячку полезной для спортсменов (shutterstock)
 Ячневая каша с брусникой и тыквой
Ячневая каша с брусникой и тыквой
 Печень в сметане с гарниром из ячки (Фото пользователя, автора рецепта)
Печень в сметане с гарниром из ячки (Фото пользователя, автора рецепта)
 Котлеты «Необычные» (Фото пользователя, автора рецепта)
Котлеты «Необычные» (Фото пользователя, автора рецепта)
 Ячневая крупа долго хранится, важно лишь время от времени открывать банку, чтобы вовремя заметить признаки порчи (shutterstock)
Ячневая крупа долго хранится, важно лишь время от времени открывать банку, чтобы вовремя заметить признаки порчи (shutterstock)



















 Slipp3ry_N00dle
Slipp3ry_N00dle ChrisLetsPlayYT
ChrisLetsPlayYT invisus64
invisus64 NoodleAddicted
NoodleAddicted TehFuriousOne
TehFuriousOne OSCgal
OSCgal jaygrum
jaygrum s_bout_20
s_bout_20 DamnitJamal
DamnitJamal ostrich-party-
ostrich-party- MilkshakeMan666
MilkshakeMan666 gbelloz
gbelloz SubstanceNo3551
SubstanceNo3551 Drazor9
Drazor9 B001eanChame1e0n
B001eanChame1e0n